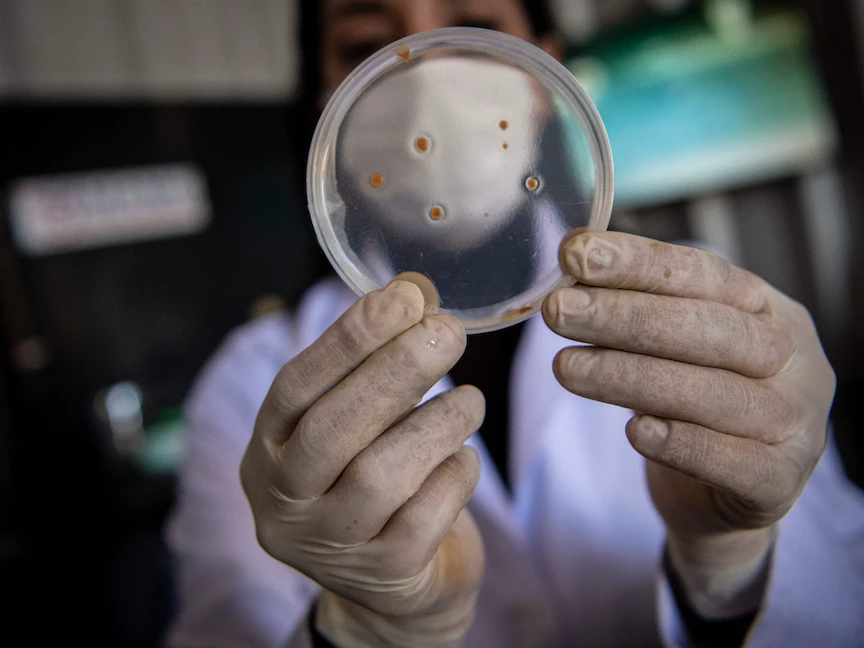

اكتشف باحثون آلية معقدة كانت غير معروفة سابقاً يستخدمها نوع من البكتيريا لمقاومة بعض المضادات الحيوية، في وقت يزداد فيه التحذير من إساءة استخدام المضادات الحيوية عالمياً، وعدم تطوير أنواع جديدة منها قادرة على التغلب على مقاومة البكتيريا للأنواع الموجودة.
وقال باحثون في دراسة نشرت، الخميس، في دورية "موليكولر سيل" (Molecular Cell) الطبية، إن بعض أنواع البكتيريا تستخدم عملية معقدة لإنقاذ نفسها من فئة المضادات الحيوية من نوع "الريفاميسين".
ويعمل المضاد الحيوي من فئة "ريفاميسين" عن طريق الارتباط بنوع من أنواع الإنزيمات المُكونة من الحمض النووي الريبوزي منقوص الأكسجين RNA polymerase، وهو مُكون رئيسي وضروري لحياة البكتيريا، ويؤدي أدواراً متنوعة في الخلية.
لكن العلماء اكتشفوا أن البكتيريا التي توجد على نطاق واسع في البيئة وفي بعض مسببات الأمراض البشرية، طورت بروتيناً يمكنه طرد المضاد الحيوي من بوليميراز الحمض النووي الريبي.
وبمجرد إخراج الريفاميسين من مكانه، تستخدم البكتيريا بروتينات مُكيَّفة خصيصاً لمهاجمته وتدميره.
خدعة جديدة تماماً
الباحث جيري رايت، الذي يقود الرابطة العالمية للأوبئة والتهديدات البيولوجية، قال إن "ما اكتشفناه هو خدعة جديدة تماماً في أكمام البكتيريا للتهرب من هذه الفئة من المضادات الحيوية".
ويُظهر الاكتشاف أن آليات مقاومة مضادات البكتيريا أكثر تعقيداً وتطوراً مما كان العلماء يعتقدونه سابقاً.
ويقوم رايت وزملاؤه الآن بتمشيط قاعدة بياناتهم التي تضم عشرات الآلاف من العينات، لمعرفة ما إذا كانت أنواعاً أخرى من البكتيريا تستخدم عمليات مماثلة للتهرب من المضادات الحيوية، وما إذا كانت تكشف عن نقاط ضعف يمكن استغلالها لإنشاء مضادات حيوية جديدة مطلوبة بشكل عاجل.
وقال رايت إن هذا الاكتشاف "يجدد حماسه لإيجاد وكشف الطرق الأخرى التي تستخدمها البكتيريا لضمان بقائها على قيد الحياة".
تهديد خطير
ويواجه العالم مشكلة مقاومة البكتيريا للمضادات الحيوية منذ سنوات طويلة، وتعتبر منظمة الصحة العالمية هذه المشكلة تهديداً صحياً "خطيراً للغاية".
وقال رايت: "في كل مرة نعتقد أننا اكتشفنا كل الطرق التي تقاوم بها البكتيريا المضادات الحيوية، يأتي شيء من هذا القبيل، ليذكرنا بأن هناك حيل لم نفكر بها من قبل".
على الرغم من أن فعالية البنيسلين والريفاميسين وغيرها من علاجات المضادات الحيوية الراسخة تتضاءل فعاليتها بسرعة، إلا أن معظم شركات الأدوية لا تعمل بنشاط على تطوير مضادات حيوية جديدة.
ويقول الباحثون إن اكتشاف الأدوية وتطويرها مكلف للغاية، وإن العائد المالي على الاستثمار في المضادات الحيوية سيكون منخفضاً نظراً لأنها لا تدر قدراً كبيراً من الإيرادات، مثل الأدوية الموصوفة التي يستخدمها مرضى الأمراض المزمنة لسنوات طويلة.




